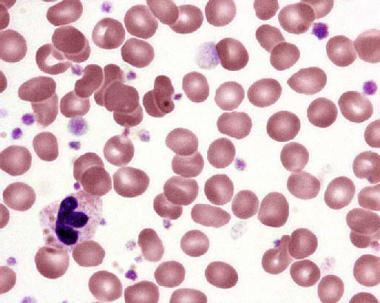

Enolase is a glycolytic enzyme that catalyzes the conversion of 2-phosphoglycerate to phosphoenolpyruvate. Enolase exists in the form of several tissue-specific isoenzymes, consisting of homo or heterodimers of 3 different monomer-isoforms (alpha, beta, and gamma). Neuron specific enolase (NSE) is a 78 kD gamma-homodimer and represents the dominant enolase-isoenzyme found in neuronal and neuroendocrine tissues. Its levels in other tissues, except erythrocytes, are negligible. The biological half-life of NSE in body fluids is approximately 24 hours.
Due to this organ-specificity, concentrations of NSE in serum or, more commonly, cerebrospinal fluid (CSF), are often elevated in diseases which result in relative rapid (hours/days to weeks, rather than months to years) neuronal destruction. Measurement of NSE in serum of CSF can therefore assist in the differential diagnosis of a variety of neuron-destructive and neurodegenerative disorders. The most common application is in the differential diagnosis of dementias, where elevated CSF concentrations support the diagnosis of rapidly progressive dementias, such as Creutzfeldt-Jacob Disease. NSE might also have utility as a prognostic marker in neuronal injury. There is, for example, increasing evidence that elevated serum NSE levels correlate with a poor outcome in coma, in particular when caused by hypoxic insult.
NSE is also frequently overexpressed by neural crest-derived tumors. Up to 70% of patients with small cell lung carcinoma (SCLC) have elevated serum NSE concentrations at diagnosis, and approximately 90% of patients with advanced SCLC will have serum levels above the healthy reference range. Other neuroendocrine tumors with frequent expression of NSE include carcinoids (up to 66% of cases), islet cell tumors (typically <40% of cases), and neuroblastoma (exact frequency of NSE expression unknown). NSE levels in NSE-secreting neoplasms correlate with tumor mass and tumor metabolic activity. High levels have therefore some negative prognostic value. Falling or rising levels are often correlated with tumor shrinkage or recurrence, respectively.
Serum neuron-specific enolase (NSE) measurement has its greatest utility in the follow-up of patients with tumors of any type that have been shown to secrete NSE. With successful treatment, serum concentrations should fall with a half-life of approximately 24 hours. Persistent NSE elevations in the absence of other possible causes (see Cautions) suggest persistent tumor. Rising levels indicate tumor spread, or in patients who had previously become NSE negative, recurrence.
In the context of a patient with a lung mass, disseminated malignancy of unknown origin or symptoms suggestive of paraneoplastic disease without identifiable tumor, elevated NSE suggests an underlying small cell lung carcinoma (SCLC).
In patients with suspected carcinoid, islet cell tumor, or neuroblastoma, who have no clear elevations in the primary tumor markers used to diagnose these conditions, an elevated serum NSE level supports the clinical suspicion.
1.Carcinoid: chromogranin A, urinary 5-hydroxyindoleacetic acid, serum/blood 5-hydroxytryptamine
2.Islet cell tumors: variety of peptide and amine-derived hormones, chromogranin A
3.Neuroblastoma: vanillylmandelic acid and homovanillic acid
When considered alongside established outcome predictors of coma, such as Glasgow coma scale and other clinical predictors (papillary light responses, corneal reflexes, motor responses to pain, myoclonus, status epilepticus), electroencephalogram, sensory evoked potentials, measurement of serum NSE concentrations provides additional information. Elevated levels are indicative of a poor outcome. Currently, no established algorithms exist to combine serum NSE concentrations and the various other predictors into a composite score that gives clear predictive outcome information. The NSE measurement therefore needs to be considered in a qualitative or semi-quantitative fashion and carefully weighed against other predictors by a physician experienced in examining and managing coma patients.
All neuron-specific enolase (NSE) test results must be considered in the clinical context, and interferences or artifactual elevations should be suspected if the clinical NSE test results are at odds with the clinical picture or other tests. The laboratory should be contacted for assistance in these situations.
Hemolysis can lead to significant artifactual NSE elevations, since erythrocytes contain NSE.
Hemoglobin concentrations as low as 20 mg/dL were found to have an adverse effect on NSE testing.
Proton pump inhibitor treatment, hemolytic anemia, hepatic failure, and end stage renal failure can also result in artifactual NSE elevations.
Other false positives depend on the treating context. When performing NSE testing for tumor diagnosis or follow-up, epileptic seizure, brain injury, encephalitis, stroke, and rapidly progressive dementia might result in false-positive results. On the other hand, when NSE testing is performed to assist in neurological diagnosis, NSE-secreting tumors can represent a source of false-positive results.
NSE values can vary significantly between methods/assays. Serial follow-up should be performed with the same assay. If assays are changed, patients should be re-baselined. This assay is an immunometric assay, and can therefore in rare situations be affected by false low results in the presence of extremely high NSE concentrations ("hooking") or autoantibodies to NSE, as well as by false results in the presence of heterophile antibodies.



 Contact Us
Contact Us






 Hospitals
Hospitals
 Doctors
Doctors
 Diagnostic
Diagnostic
 Pharmacy
Pharmacy
 Health Tips
Health Tips
 Blog
Blog